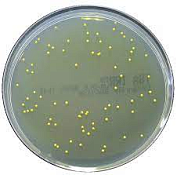

Наборы питательных подушечек
от 10 сум / упаковка
Звоните по телефону:
Дата последнего обновления: 21 ноября, 2025
Наборы питательных подушечек, подушечки
с обезвоженной средой в стандартной среде
TTC и мембранным фильтром с сеткой 0,45
мкм
Питательные картонные подложки для определения микроорганизмов в комплекте с мембранными фильтрами для диспенсера Microsart e.motion, диаметр 47мм, диаметр пор 0,45мкм, 100 шт/уп
Организация:
Lab & Production Solutions
Описание:
ООО Lab and Production Solutions – является специализированным поставщиком аналитического и лабораторного оборудования на территории Центральной Азии и СНГ. Мы тесно сотрудничаем с ведущими европейскими производителями лабораторного оборудования, основная часть которых выпадает на промышленный и новаторский рынок Германии. Мы стремимся обеспечить клиентов высококачественным оборудованием с максимальным уровнем сервисной поддержки для эффективного решения технологических и аналитических задач. Мы оказываем широкий спектр услуг в оснащении лабораторий предприятий машиностроительного, нефтегазодобывающего и перерабатывающего комплекса, учреждений здравоохранения, санитарно-эпидемиологических служб, инстанций судебной экспертизы, научных организаций, пищевой, фармацевтической, сельскохозяйственной промышленности, а также учреждений в сфере науки и образования. И, к счастью, мы этим не ограничиваемся. Компания занимается полным обеспечение потребностей клиента в лабораторном оборудовании, в т.ч. лабораторной посуде, лабораторной мебели и многом др. С этой целью, к нашей работе привлекаются эксперты из-за рубежа, готовые единовременно и с учетом Ваших требований, а также в балансе со своими знаниями и полученным опытом, представить комплексное решение к поставленной задаче. Компания Lab and Production Solutions имеет персонал, который может Вас проконсультировать по заинтересовавшему Вас типу оборудования, подобрать и поставить под ваши нужды качественное лабораторное оборудование, а также провести установку и обучение сотрудников. Благодаря долгому и тесному сотрудничеству с производителями лабораторного оборудования МЫ ОСУЩЕСТВЛЯЕМ полный спектр пост-продажного обслуживания: монтаж, пуско-наладку, гарантийное, пост-гарантийное обслуживание и обучение персонала конечного пользователя. Наша интернет-магазин стал одним из первых магазинов, осуществляющих on-line продажу лабораторного и аналитического оборудования в регионе. На данный момент мы представляем собой солидную компанию, владеющую интернет–магазином и имеющую в своей сети единый call-центр, который регулирует всю деятельность нашего магазина, отдел продаж, службу доставки, собственный склад. За это время у нас сложились партнерские отношения с ведущими производителями, позволяющие предлагать высококачественную продукцию по конкурентоспособным ценам. Наши возможности • Быстрая доставка • Широкий ассортимент • Бонусы и подарки • Отличное обслуживаение • Профессиональный менеджеры • Гарантия на все товары • Надежные поставщики • Сезонные скидки • Программа лояльности • Карты постоянных клиентов Мы всегда рады общению с нашими клиентами. Если у вас есть какие-либо пожелания, предложения, замечания, касающиеся работы нашего Интернет-магазина - пишите нам, и мы с благодарностью примем ваше мнение во внимание.
Адрес:
г. Ташкент, Учтепинский р-н, ул. Ширин 44Б
Телефон:
 Lab & Production Solutions
+998 94 777 44 48
Lab & Production Solutions
+998 94 777 44 48
Скажите продавцу, что получили его номер телефона на Stroyka.uz. Уточняйте о возможных скидках.
Скажите продавцу, что получили его номер телефона на Stroyka.uz. Уточняйте о возможных скидках.
+998 94 777 44 48

Позвонить
Позвонить
 Написать
Написать











Комментарии